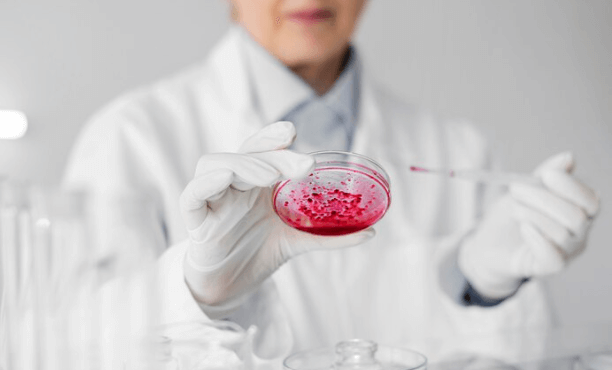

عيادات
علاج العقم
مشكلة عدم الإنجاب
في عالم الطب يواجه الأطباء، مشكلة عدم الإنجاب بشكل متكرر وتؤرق العديد من الأزواج. يبحثون عن الحلول والعلاجات التي تمكنهم من تحقيق حلم الأبوة والأمومة. ومن هنا تأتي أفضل عيادات علاج العقم
إلى الواجهة، حاملةً في طياتها الأمل والفرصة للأزواج الذين يعانون من صعوبة في تحقيق الحمل. في هذا المقال، سنقدم لك معلومات قيمة حول أفضل المعلومات عن العقم ومتى من الواجب زيارة عيادات علاج العقم وسنستعرض آلية عمل مراكز علاج العقم.

عياداتعلاج العقم

علاج العقم
العقم هو حالة عدم قدرة الزوجين على تحقيق الحمل أو الإنجاب بشكل طبيعي بعد محاولات متكررة ومنتظمة لفترة زمنية معقولة
- علاج العقم يتنوع بحسب أسبابه وظروف كل حالة. يشمل العلاج تقنيات مثل:
-
العلاجات الدوائية:
تستخدم لتحفيز الإباضة لدى النساء أو لتعزيز وظيفة الخصيتين لدى الرجال. -
الجراحة:
يمكن أن تتضمن إصلاح تشوهات في الجهاز التناسلي أو استرجاع الحيوانات المنوي ة في بعض الحالات. -
الإخصاب الصناعي:
مثل التلقيح الصناعي أو تقنيات مساعدة للإخصاب مثل الإنسجام المجهري أو تقنيات الحقن المجهري. -
الإخصاب الصناعي:
مثل التلقيح الصناعي أو تقنيات مساعدة للإخصاب مثل الإنسجام المجهري أو تقنيات الحقن المجهري. -
العلاجات الهرمونية:
تستخدم لتنظيم وتحسين الوظيفة الهرمونية المرتبطة بالإنجاب. الخيار المناسب يعتمد على تشخيص الطبيب وظروف كل حالة.

أسباب العقم
- يمكن أن يكون العقم ناتجًا عن مشكلات في الجهاز التناسلي للرجل أو المرأة أو عن عوامل أخرى
- مثل التوتر النفسي أو مشاكل صحية أخرى. يمكن أن يكون العقم مؤقتًا أو دائمًا
- يمكن أن يكون التوتر النفسي سبب العقم، ويمكن تحسين فرص الإنجاب من خلال العلاج النفسي أو الاستشارة الزوجية.
- يمكن أن يكون تغيير نمط الحياة مثل تحسين التغذية والتقليل من عوامل التوتر قد مساهم في تحسين فرص الإنجاب.
- ويمكن أن يتطلب تقديم الرعاية الطبية لتحديد أسبابه وعلاجه إذا كان ذلك ممكنًا.
- الإدمان من اهم العوامل التي تسبب عقم وينصح بزيارة عيادات ادمان المخدرات للتعافي
طرق لعلاج العقم
- توقف اختيار الطريقة المناسبة على السبب الرئيسي للعقم. يمكن استخدام العلاجات الدوائية لزيادة إنتاج البويضات لدى النساء أو تحسين وظيفة الحيوانات المنوية للرجال.
- إضافة إلى ذلك، يتضمن العلاج أيضًا تداخلات جراحية تهدف إلى تصحيح مشكلات مثل انسداد الأنابيب أو عقبات أخرى تعيق عملية الإنجاب.
ومن الطرق ايضاً تقنيات التلقيح الصناعي مثل التلقيح الصناعي داخل الرحم (IUI) وتلقيح البويضة المجهري (IVF) تعتبر أيضًا وسائل فعالة لزيادة فرص الإنجاب.
ما هي أنواع العقم
- هناك أنواع مختلفة من العقم تشمل:
-
عقم أولي (Primary Infertility):
هذا النوع من العقم يحدث عند المرأة منذ بداية حياتها الجنسية أو منذ بداية زواجها. بمعنى آخر، المرأة لم تنجب أي طفل من قبل ولا تستطيع تحقيق الحمل. -
عقم ثانوي (Secondary Infertility):
يحدث هذا النوع من العقم عند المرأة بعد أن قامت بإنجاب طفل أو أكثر في السابق. بمعنى آخر، المرأة كانت قادرة على الإنجاب في وقت مضى، ولكنها لا تستطيع تكرار هذه العملية مرة أخرى بعد وقوع حمل انتهى بإجهاض أو حمل خارج الرحم. -
عقم الرجال (Male Infertility):
يمكن أن يكون العقم أيضًا ناتجًا عن مشكلات في الرجال. على سبيل المثال، قد يكون السبب في عدم القدرة على تحقيق الحمل هو خمول الحيوانات المنوية لدى الرجل، مما يجعلها غير قادرة على الوصول إلى بويضة الأنثى وتخصيبها. - العقم يمكن أن يكون ناتجًا عن عدة أسباب مختلفة، بما في ذلك مشكلات في الجهاز التناسلي للرجل أو المرأة، مشكلات هرمونية، أمراض مزمنة، عوامل نفسية، أو توتر. يتطلب تحديد السبب الدقيق للعقم تقييماً طبياً واستشارة مع أخصائي تكاثر وعقم لاختيار أفضل مراكز علاج العقم01.


علاج العقم للنساء
دائما يواجه الأزواج مشكلة العقم عند النساء، يكون العلاج عادةً موجّهاً نحو معالجة السبب الجذري للمشكلة. تتضمن طرق العلاج الممكنة ما يلي:
علاج مشكلات الإباضة:
- لدى النساء اللواتي يعانين من مشاكل في عملية الإباضة.
- هناك أدوية تساعد في تنظيم الهرمونات وتحفيز الإباضة السليمة.
- تشمل هذه الأدوية مثل Clomiphene Citrate الذي يحفز إفراز الهرمونات من الغدة النخامية، وأدوية أخرى تزيد من نشاط الهرمونات.
- أيضًا، يمكن استخدام Metformin لتحسين استجابة الإنسولين وتعزيز الإباضة.
العلاجات الجراحية:
في حال وجود مشاكل في الأعضاء التناسلية مثل الرحم أو قنوات فالوب، يمكن أن تكون العلاجات الجراحية ضرورية لإزالة هذه العقبات واستعادة القدرة على الإنجاب.
التلقيح المخبري الخارجي “طفل الأنبوب”
في الحالات التي لا تستجيب للعلاجات التقليدية، يمكن اللجوء إلى عملية التلقيح المخبري الخارجي. تشمل هذه العملية أخذ بويضة من المرأة وعينة من الحيوانات المنوية من الرجل، ثم تتم عملية تخصيب البويضة في المختبر. بعد ذلك، يتم إعادة البويضة المخصبة إلى رحم المرأة لتتطور وتنمو هناك. ويمكن علاج العقم بالعلاج الطبيعي من خلال زياره عيادات العلاج الطبيعي
من المهم معرفة أن كل حالة تعاني من مشكلة العقم مختلفة، وبالتالي يتعين على الأزواج استشارة طبيب مختص ضمن عيادات علاج العقم لتقديم التقييم والعلاج المناسب لحالتهم الفردية.
أسباب وعوامل العقم عند النساء
- العقم عند النساء هو حالة تمنعهن من الحمل والإنجاب بشكل طبيعي. يمكن أن يكون للعديد من الأسباب والعوامل دور في زيادة احتمالية العقم. من بين هذه الأسباب والعوامل:
-
اضطرابات الهرمونات:
يمكن أن تؤدي اضطرابات في إفراز الهرمونات مثل هرمون اللوتين (LH) وهرمون المنبه للجريب (FSH) إلى عدم انتظام عملية الإباضة، مما يعوق الإنجاب. هذه الاضطرابات تجعل الدورة الشهرية غير منتظمة. - تتسبب هذه المتلازمة في تغييرات في الهرمونات وتزيد من مستويات الهرمونات الذكرية، مما يؤثر على عملية الإباضة. 3. خلل في تطور الجسم الأصفر: إذا لم يتم إفراز كمية كافية من البروجيستيرون بعد الإباضة، يمكن أن يؤدي ذلك إلى عدم قدرة الرحم على استقبال البويضة المخصبة.
-
فشل مبيضي مبكر:
يمكن أن يحدث نتيجة لمرض ذاتي المناعة يؤدي إلى تلف المبيضين وانخفاض مستويات الإستروجين. -
انسداد القنوات الفالوبية:
إذا حدث انسداد في قنوات فالوب، تكون البويضة غير قادرة على الوصول إلى الرحم، مما يعيق الإنجاب. الانسداد يمكن أن يكون ناتجًا عن عدوى أو تشكيل الالتصاقات. -
عوامل خطر أخرى:
هناك عوامل أخرى تزيد من احتمالية العقم، مثل العمر المتقدم، التدخين، السمنة، النشاط الجنسي الغير آمن، واستهلاك القهوة والكحول بكميات زائدة.
من المهم معالجة هذه العوامل والأسباب بعناية، والتشاور مع أخصائي ضمن عيادة علاج العقم للرجال أاو من خلال موقع عيادات لتحديد أفضل استراتيجية علاجية تتناسب مع كل حالة على حدة.
افضل طبيب علاج العقم للرجال
أفضل طبيب لعلاج العقم للرجال هو طبيب متخصص في مجال الطب التناسلي وعلاج العقم. يجب أن يتوفر لديه الخبرة والتحديث المستمر للمعلومات في مجال علاج العقم. يجب أن يكون قادراً على التواصل بشكل فعال مع المرضى وشرح الخيارات المتاحة بوضوح.
ينبغي للطبيب أن يكون حساساً للأوضاع النفسية والعاطفية للمرضى، ويقدم الدعم النفسي اللازم. كما عليه احترام خصوصية المرضى وضمان سرية معلوماتهم الطبية. وعيادته مجهزة بأحدث التقنيات والمعدات الطبية. التفهم وبناء علاقة صداقة مع المريض يمكن أن يكون مفيدًا.
كما يمتلك سجل طبي جيد من حيث نجاح العلاجات السابقة لحالات العقم. يجب على الطبيب أن يتعاون مع فريق طبي متخصص وقادر على تقديم التوجيه والتثقيف للمرضى حول الأسباب المحتملة للعقم والخيارات المتاحة للعلاج.
علاج العقم و الضعف الجنسي بالخلايا الجذعية
علاج العقم عند الرجال باستخدام الخلايا الجذعية هو عبارة عن إجراء طبي يستهدف تحسين قدرة الرجل على الإنجاب عن طريق تجديد وتعزيز وظيفة الأعضاء التناسلية والإنتاج الحيواني. يتم ذلك بتطبيق الخلايا الجذعية في المناطق المختلفة للعضو التناسلي، والفوائد المرجوة من هذا العلاج تشمل:
الحصول على انتصاب أفضل وقدرة جنسية أفضل:
تساعد الخلايا الجذعية في تحسين وظيفة الأعضاء التناسلية وزيادة قدرة الرجل على الانتصاب بشكل أقوى لفترة أطول.
زيادة الرغبة الجنسية:
يمكن أن تساعد هذه العلاجات على استعادة التوازن الفيزيائي في الأعضاء التناسلية وبالتالي زيادة الرغبة الجنسية.
تحسين تدفق الدم:
تساهم الخلايا الجذعية في زيادة تدفق الدم إلى الأعضاء التناسلية، مما يساعد في تحسين الانتصاب والأداء الجنسي.
الاستغناء عن الأدوية:
في بعض الحالات، يمكن لهذه العلاجات أن تساعد الرجل على التخلص من الحاجة للأدوية المساعدة في الانتصاب.
باختصار، استخدام الخلايا الجذعية لعلاج الضعف الجنسي للرجال يهدف إلى تحسين وظيفة الأعضاء التناسلية وزيادة قدرة الرجل على الإنجاب وتحسين الأداء الجنسي بشكل عام.

المدة التي يستغرقها علاج العقم
مدة علاج العقم تعتمد على العديد من العوامل بما في ذلك سبب العقم وحالة الصحة العامة للزوجين. في بعض الحالات، يمكن تحقيق الحمل بشكل طبيعي في غضون 3 إلى 6 أشهر. ولكن في الحالات التي تتطلب علاجًا خاصًا، قد تمتد مدة العلاج لفترة أطول.
على سبيل المثال، إذا كان العقم ناجمًا عن مشكلة في عملية الإباضة، يمكن أن تستغرق العلاجات للتنظيم الهرموني وتحسين الإباضة بضعة أشهر. وفي حالات العقم الذكوري، قد يحتاج الرجل إلى علاج لعدة أشهر لتحسين جودة وعدد الحيوانات المنوية.
علاوة على ذلك، تعتمد مدة العلاج على الاستجابة الفردية للعلاجات والتدخلات المطلوبة. هنا يأتي دور تعاون الزوجين مع الأطباء والمتخصصين لتحديد المدة المناسبة للعلاج والمتابعة اللازمة.
بشكل عام، من المهم فهم أن مدة العلاج تكون متغيرة وتعتمد على حالة كل زوج على حدة. حيث الالتزام بتوجيهات الفريق الطبي والاستمرار في متابعة العلاج لتحقيق الحمل السليم.

حالات العقم التي لا يمكن علاجها عند الرجال
هناك حالات من العقم عند الرجال يمكن أن تكون صعبة أو غير قابلة للعلاج بشكل كامل، وتشمل:
القيلة الدوالية:
القيلة الدوالية هي توسع في الأوردة في الخصيتين، وقد تؤثر على جودة وعدد الحيوانات المنوية. في بعض الحالات، يمكن إجراء جراحة لعلاج هذه المشكلة، لكن في حالات متقدمة، قد لا تكون الجراحة فعالة.
العدوى:
بعض العدوى البكتيرية يمكن أن تتسبب في تلف الأنسجة الخصوصية وتضر بوظيفة الخصيتين، وفي بعض الأحيان يمكن أن تكون هذه الأضرار دائمة.
مشكلات القذف:
بعض الرجال يعانون من مشكلات في عملية القذف مثل القذف الوراثي، وهذه المشكلة قد تكون صعبة العلاج.
الأجسام المضادة التي تهاجم الحيوانات المنوية:
في بعض الحالات، يمكن أن تكون هناك أجسام مضادة تهاجم الحيوانات المنوية وتعيق قدرتها على الوصول إلى البويضة.
الأورام:
وجود أورام في الخصيتين يمكن أن يؤثر على وظيفتهما ويكون صعب العلاج.
الخصيتان المعلقتان:
حالة تتضمن انخفاض وضع الخصيتين في الكيس الصفني، وهذا يمكن أن يؤدي إلى مشاكل في درجة حرارة الخصيتين وتأثيرهما على إنتاج الحيوانات المنوية.
اختلال توازن الهرمونات:
بعض اختلالات توازن الهرمونات قد تكون صعبة العلاج وتؤثر على إنتاج الحيوانات المنوية.
خلل في الأنابيب التي تنقل الحيوانات المنوية:
تلف في الأنابيب التي تنقل الحيوانات المنوية من الخصيتين يمكن أن يكون صعب العلاج.
بالرغم من أن بعض هذه الحالات يمكن علاجها جزئيًا أو بشكل مؤقت، إلا أنها قد تظل تحتاج إلى متابعة دائمة ورعاية طبية مكثفة. في بعض الأحيان، قد تكون هذه المشكلات غير قابلة للعلاج بشكل كامل، وقد يحتاج الأزواج في مثل هذه الحالات إلى تجربة خيارات أخرى مثل تقنيات الإخصاب المساعد.

أصعب حالات العقم عند الرجال
يعد العقم الناتج عن القذف المرتجع من بين أصعب وأكثر الحالات تعقيدًا فيما يتعلق بالعقم عند الرجال. تحدث هذه الحالة عندما يتم دفع الحيوانات المنوية مرة أخرى إلى المثانة بدلاً من خروجها من الجسم عبر القضيب أثناء القذف.
ونتيجة لهذا، يتم تخزين السائل المنوي في المثانة، مما يؤدي إلى عدم خروجه من الجسم عند بلوغ النشوة الجنسية. هذه الحالة تعد واحدة من أصعب حالات العقم عند الرجال وتتطلب اهتمامًا وعلاجًا خاصين للتعامل معها.
الاسئلة الشائعة
ما الذي يسبب العقم عند الرجال ؟
العقم عند الرجال يمكن أن ينجم عن مشاكل في الحيوانات المنوية، توازن الهرمونات، الأعضاء التناسلية، العدوى، الأورام، ومشاكل جينية.
ما هو العقم الجنسي ؟
العقم الجنسي هو حالة يصعب فيها على الرجل تحقيق الانتصاب أو القذف بشكل طبيعي، ويمكن أن يكون هذا النوع من العقم نفسيًا أو عضويًا.
هل يمكن الشفاء من العقم عند الرجال؟
العديد من الحالات يمكن علاجها بنجاح بواسطة التدابير الطبية والعلاجات المناسبة. ومع ذلك، ليست جميع حالات العقم قابلة للعلاج بشكل كامل.
هل يستطيع الرجل العقيم الإنجاب؟
يعتمد ذلك على سبب العقم وعلى الإجراءات والعلاجات المتاحة. في بعض الحالات، يمكن للرجل العقيم الإنجاب باستخدام تقنيات الإخصاب المساعدة.
ما هي حالات العقم التي لا يمكن علاجها عند الرجال؟
بعض حالات العقم عند الرجال التي قد لا تكون قابلة للعلاج بشكل كامل، مثل:
القيلة الدوالية.
العدوى الشديدة والدائمة.
مشاكل خلقية خطيرة في الأعضاء التناسلية.
أورام خبيثة في الجهاز التناسلي.
حالات وراثية نادرة وخطيرة.

